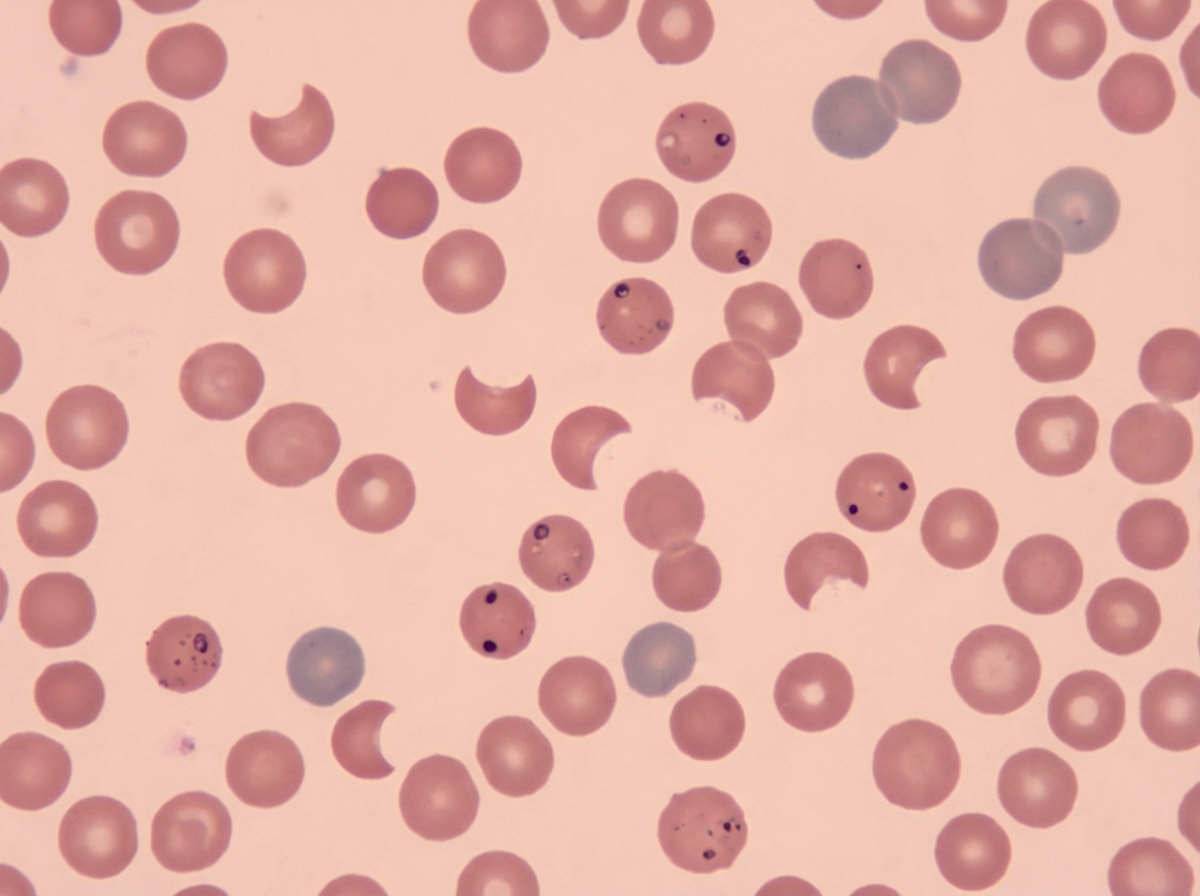
Image for question 5

A diabetic female on Isoniazid (INH) and Rifampicin for tuberculosis developed Deep Vein Thrombosis (DVT). She was started on Warfarin, but her Prothrombin Time (PT) is not elevated. What is the next appropriate step in management?
Which antibiotic is MOST frequently implicated as a cause of drug-induced liver injury (DILI)?
Among the drugs used for Hepatitis B antiviral therapy, which of the following has the highest tendency for peripheral neuropathy?
Which of the following drugs should not be given in renal failure?
A 30-year-old male presented with a skin lesion in his right axilla. A presumptive diagnosis of staphylococcal skin carbuncle was made and the patient was treated with empiric trimethoprim/sulfamethoxazole. After 2 days, the patient presented to the emergency department with excessive weakness, abdominal pain, and dark-colored urine. On examination, vital signs were normal, and jaundice was present. Laboratory studies showed a drop in Hb from 14 g/dl to 8 g/dl and a rise in bilirubin levels. Urine dipstick was positive for bilirubin. Peripheral blood smear findings are suggestive of a specific condition. What is the most likely diagnosis for this patient?
Which metabolic abnormality is caused by cyclosporine?
A 40-year-old lady presents to casualty with abdominal pain and vomiting. She also reports hearing people conspiring to harm her, and visual hallucinations. These symptoms started along with the abdominal pain following the use of barbiturates. What is the most likely diagnosis?
Which of the following drugs is most commonly associated with noninfectious chronic meningitis due to drug hypersensitivity?
Which of the following antitubercular drug combinations is preferred in patients with severe liver disease?
All of the following cause hypertension except?
Explanation: ### Explanation **1. Why LMWH is the Correct Choice:** The patient is taking **Rifampicin**, a potent **cytochrome P450 (CYP3A4 and CYP2C9) enzyme inducer**. Warfarin is metabolized by these enzymes; therefore, Rifampicin significantly increases Warfarin metabolism, leading to subtherapeutic levels and a failure to elevate the Prothrombin Time (PT/INR). In the acute management of DVT, achieving rapid and reliable anticoagulation is critical [1]. Since the drug interaction makes Warfarin unpredictable and difficult to titrate, switching to **Low Molecular Weight Heparin (LMWH)** is the most appropriate step. LMWH does not rely on the CYP450 system and provides immediate, predictable anticoagulation [2]. **2. Analysis of Incorrect Options:** * **Option A (Increase Warfarin dose):** While theoretically possible, the induction effect of Rifampicin is so profound that extremely high doses of Warfarin would be required, making the INR highly unstable and increasing the risk of toxicity if Rifampicin is later discontinued. * **Option B (Replace with Acenocoumarol):** Acenocoumarol is also a Vitamin K antagonist metabolized by the liver; it shares the same metabolic pathways and drug interactions as Warfarin [1]. * **Option C (Switch Ethambutol for Rifampicin):** Rifampicin is a cornerstone of Short Course Chemotherapy (SCC) for TB. It should not be discontinued or replaced with a less potent drug like Ethambutol solely to accommodate Warfarin, as this risks treatment failure or MDR-TB. **3. NEET-PG High-Yield Pearls:** * **Rifampicin:** The "Great Inducer." It reduces the efficacy of Warfarin, Oral Contraceptive Pills (OCPs), Sulfonylureas, and Digoxin. * **Isoniazid (INH):** Conversely, INH is a CYP enzyme **inhibitor**, but in this clinical scenario, the inducing effect of Rifampicin dominates. * **Management Rule:** When a patient on Rifampicin requires anticoagulation, LMWH or Fondaparinux are preferred over Vitamin K antagonists due to predictable pharmacokinetics [2].
Explanation: **Amoxicillin-clavulanic acid (Co-amoxiclav)** is the most common cause of drug-induced liver injury (DILI) worldwide. The injury is typically **idiosyncratic** and characterized by a **cholestatic** pattern (elevated alkaline phosphatase and bilirubin), though mixed patterns can occur [1]. Interestingly, the injury is specifically attributed to the **clavulanic acid** component rather than the amoxicillin itself. It usually manifests within 1–3 weeks after starting the drug, but can occur even after the course is completed. **Analysis of Incorrect Options:** * **Oxacillin:** While anti-staphylococcal penicillins (like Oxacillin and Nafcillin) can cause transient elevations in transaminases or hepatitis, they are statistically less frequent causes of DILI compared to Co-amoxiclav [2]. * **Erythromycin:** Classically associated with **cholestatic hepatitis** (especially the estolate formulation), it was historically a major cause of DILI. However, its usage has declined in favor of newer macrolides, and it remains less frequent than Co-amoxiclav in modern epidemiological studies. * **Doxycycline:** Tetracyclines are generally associated with microvesicular steatosis (fatty liver), particularly with high-dose IV administration in pregnant women. Doxycycline is rarely implicated in severe DILI. **High-Yield Clinical Pearls for NEET-PG:** * **Most common drug class for DILI:** Antibiotics (overall). * **Most common single agent for DILI:** Amoxicillin-clavulanic acid. * **Pattern of Injury:** Co-amoxiclav typically causes a **cholestatic** pattern (Pruritus + Jaundice) [1]. * **Risk Factors:** Older age and male sex increase the risk for Co-amoxiclav-induced DILI. * **Other common culprits:** Isoniazid (Hepatocellular/Necrotic pattern), Valproate (Microvesicular steatosis), and Nitrofurantoin (Autoimmune-like hepatitis).
Explanation: **Explanation:** The correct answer is **Stavudine (d4T)**. **1. Why Stavudine is correct:** Stavudine is a Nucleoside Reverse Transcriptase Inhibitor (NRTI). Its primary mechanism of toxicity involves the inhibition of **Mitochondrial DNA polymerase-gamma**. This leads to mitochondrial dysfunction, which clinically manifests as **distal symmetrical peripheral neuropathy** and lactic acidosis. Among the NRTIs, the "d-drugs" (Stavudine, Didanosine, and Zalcitabine) have the highest affinity for polymerase-gamma, making them the most notorious for causing nerve damage. **2. Analysis of Incorrect Options:** * **Lamivudine (3TC):** While also an NRTI used in both HIV and Hepatitis B, it is one of the least toxic drugs in its class. It has a very low affinity for mitochondrial DNA polymerase and rarely causes neuropathy. * **Zidovudine (AZT):** The hallmark side effect of Zidovudine is **bone marrow suppression** (anemia and neutropenia) and myopathy, rather than peripheral neuropathy. * **Nevirapine:** This is a Non-Nucleoside Reverse Transcriptase Inhibitor (NNRTI). Its most significant adverse effects are **hepatotoxicity** and severe skin rashes (including Stevens-Johnson Syndrome), not neuropathy. **3. NEET-PG High-Yield Pearls:** * **Mnemonic for Neuropathy:** Remember the **"3 Ds"** for peripheral neuropathy: **D**idanosine, **D**eoxycytidine (Zalcitabine), and **D**4T (Stavudine). * **Stavudine** is also strongly associated with **Lipoatrophy** (loss of subcutaneous fat from the face and limbs). * For Chronic Hepatitis B, **Tenofovir** and **Entecavir** are currently the preferred first-line agents due to high potency and a high genetic barrier to resistance.
Explanation: **Explanation:** The correct answer is **Methicillin**. The primary reason Methicillin is contraindicated in renal failure is its significant association with **Acute Interstitial Nephritis (AIN)** [1]. Methicillin is a potent nephrotoxin that can cause hypersensitivity-mediated renal damage, potentially worsening pre-existing renal impairment or causing acute kidney injury [3]. Due to this high risk of nephrotoxicity, Methicillin has largely been replaced in clinical practice by safer alternatives like Cloxacillin or Nafcillin. **Analysis of Options:** * **Methicillin (Correct):** It is primarily excreted by the kidneys and is the classic prototype drug for drug-induced AIN [1]. Its use is avoided in patients with renal compromise to prevent further parenchymal damage [3]. * **Clindamycin:** This drug is primarily metabolized by the **liver** and excreted in the bile. Therefore, it does not require dose adjustment in renal failure and is considered safe. * **Amoxicillin:** While Amoxicillin is renally excreted, it is not inherently nephrotoxic. In cases of renal failure, the **dose is adjusted** (decreased frequency), but the drug is not strictly contraindicated. * **Rifampicin:** This is primarily metabolized by the **liver** and eliminated via the fecal/biliary route. It is safe to use in renal failure without significant dose modification. **NEET-PG High-Yield Pearls:** 1. **Safe in Renal Failure (No dose adjustment):** Clindamycin, Erythromycin, Rifampicin, Doxycycline, and Ceftriaxone. 2. **Drugs causing AIN:** Penicillins (Methicillin), NSAIDs, Sulphonamides, and Diuretics [1]. 3. **Doxycycline** is the tetracycline of choice in renal failure because it is excreted via the gut (biliary). 4. **Aminoglycosides and Amphotericin B** are the most common causes of Acute Tubular Necrosis (ATN) in clinical settings [2].
Explanation: ***Glucose-6-phosphate dehydrogenase (G6PD) deficiency*** - **Trimethoprim/sulfamethoxazole** is a known trigger for **oxidative hemolysis** in G6PD deficiency, causing rapid drop in Hb from 14 to 8 g/dl with **dark urine** and **jaundice**. - Peripheral blood smear would show **bite cells** and **Heinz bodies**, characteristic findings of oxidative hemolytic anemia in G6PD deficiency. *Hemolytic-uremic syndrome* - Typically presents with the **triad** of **hemolytic anemia**, **thrombocytopenia**, and **acute kidney injury**, often following **diarrheal illness**. - Associated with **schistocytes** on peripheral smear and **elevated creatinine**, which are not described in this case. *Hereditary spherocytosis* - Characterized by **chronic hemolysis** with **spherocytes** on peripheral smear and **osmotic fragility test** positivity. - Usually presents with **splenomegaly** and **gallstones** from chronic hemolysis, not acute drug-induced hemolysis. *Iron deficiency anemia* - Develops **gradually** over months with **microcytic hypochromic** red blood cells and **low ferritin** levels. - Does not cause **acute hemolysis**, **dark urine**, or **jaundice** as seen in this patient.
Explanation: **Explanation:** Cyclosporine is a Calcineurin Inhibitor (CNI) widely used as an immunosuppressant in organ transplantation and autoimmune disorders. **Why Hyperkalemia is correct:** Cyclosporine causes **Hyperkalemia** primarily through two mechanisms: 1. **Renal Vasoconstriction:** It induces potent vasoconstriction of the afferent arterioles, reducing renal blood flow and the Glomerular Filtration Rate (GFR). 2. **Hyporeninemic Hypoaldosteronism:** It suppresses the production of renin and aldosterone. Reduced aldosterone levels lead to decreased potassium excretion in the distal nephron [1]. Additionally, it inhibits the mineralocorticoid receptor-mediated sodium-potassium exchange, further elevating serum potassium levels. **Why other options are incorrect:** * **Hypokalemia:** This is incorrect because cyclosporine consistently impairs potassium excretion rather than promoting it. * **Hypercalcemia/Hypocalcemia:** Cyclosporine does not significantly impact calcium homeostasis directly. However, it is more commonly associated with **Hypomagnesemia** due to renal magnesium wasting. **High-Yield Clinical Pearls for NEET-PG:** * **The "Hyper" Mnemonic for Cyclosporine side effects:** **Hyper**kalemia, **Hyper**tension, **Hyper**lipidemia, **Hyper**glycemia, and **Hyper**trichosis (Hirsutism). * **Gingival Hyperplasia:** A classic physical finding associated with cyclosporine (also seen with Phenytoin and Nifedipine). * **Nephrotoxicity:** This is the most common dose-limiting side effect. * **Comparison:** Unlike Cyclosporine, **Tacrolimus** (another CNI) does not cause hirsutism or gingival hyperplasia but is more likely to cause post-transplant diabetes mellitus.
Explanation: ### Explanation **Correct Answer: A. Acute Intermittent Porphyria (AIP)** The clinical triad of **abdominal pain, neuropsychiatric symptoms (hallucinations/paranoia), and a history of drug triggers** is classic for Acute Intermittent Porphyria [1]. * **Pathophysiology:** AIP is an autosomal dominant disorder caused by a deficiency of **Porphobilinogen (PBG) deaminase**. This leads to the accumulation of toxic heme precursors, ALA and PBG [1]. * **The Trigger:** Barbiturates are potent inducers of the **Cytochrome P450** system. This increases the demand for heme, stimulating the enzyme **ALA synthase**, which results in a massive surge of toxic precursors, precipitating an acute attack. Specific triggers identified include drugs such as anticonvulsants (barbiturates), sulphonamides, and oestrogens [1]. * **Clinical Presentation:** Often described as the "Little Imitator," it presents with severe "painful abdomen" (but no signs of peritonitis), peripheral neuropathy, and psychiatric disturbances (psychosis, anxiety) [1]. **Why Incorrect Options are Wrong:** * **B. Ketoacidosis:** While it causes abdominal pain and vomiting, it typically presents with Kussmaul breathing, dehydration, and altered sensorium, rather than complex auditory/visual hallucinations triggered by barbiturates. * **C. Hyperthyroidism:** Can cause anxiety and palpitations (Thyroid Storm), but the specific association with barbiturate-induced abdominal pain and psychosis is not characteristic. * **D. Conversion Disorder:** This is a diagnosis of exclusion. The presence of a specific pharmacological trigger (barbiturates) and severe systemic symptoms points toward an organic metabolic cause. **High-Yield NEET-PG Pearls:** * **The 5 P's of AIP:** **P**ainful abdomen, **P**olyneuropathy, **P**sychological disturbances, **P**ink urine (on standing/exposure to light), and **P**recipitated by drugs [1]. * **Diagnosis:** Elevated urinary **PBG** levels during an attack (Hoesch test or Watson-Schwartz test). * **Management:** Avoid triggers, administer **Intravenous Hemin** (inhibits ALA synthase), and give **High-dose Glucose** (suppresses ALA synthase). * **Safe Drugs:** Morphine, Aspirin, Penicillin. * **Unsafe Drugs:** Barbiturates, Sulfonamides, Oral Contraceptive Pills [1].
Explanation: The clinical entity described is **Drug-Induced Aseptic Meningitis (DIAM)**. This is a rare but important hypersensitivity reaction (Type III or IV) characterized by meningeal inflammation [1] in the absence of an infectious pathogen. **Why Ibuprofen is Correct:** **NSAIDs**, particularly **Ibuprofen**, are the most frequently implicated class of drugs causing DIAM. It typically presents with classic meningeal signs (fever, headache, neck stiffness) within hours of ingestion [1],[2]. A key diagnostic feature is that the symptoms resolve rapidly upon drug discontinuation but recur promptly upon re-exposure. It is most commonly seen in patients with underlying autoimmune conditions, especially **Systemic Lupus Erythematosus (SLE)**. **Analysis of Incorrect Options:** * **Acetaminophen:** While a common analgesic, it is not associated with aseptic meningitis. Its primary toxicity is dose-dependent hepatotoxicity. * **Acyclovir:** Acyclovir is more commonly associated with **obstructive uropathy** (due to crystal formation in renal tubules) or **neurotoxicity** (confusion, tremors), but not typically hypersensitivity-mediated meningitis. * **Beta-lactams:** While antibiotics like Penicillins and Cephalosporins [2] can cause DIAM, they are less frequently the culprit compared to Ibuprofen in clinical practice and board examinations. **High-Yield Pearls for NEET-PG:** * **CSF Findings in DIAM:** Neutrophilic pleocytosis (mimicking bacterial meningitis), elevated protein, and normal glucose levels. * **Common Culprits (Mnemonic: "N-A-I-L"):** **N**SAIDs (Ibuprofen), **A**ntibiotics (TMP-SMX), **I**VIG, **L**amotrigine. * **Risk Factor:** Patients with **SLE** or Mixed Connective Tissue Disease (MCTD) are at a significantly higher risk for Ibuprofen-induced DIAM.
Explanation: **Explanation:** The management of tuberculosis in patients with severe liver disease (such as cirrhosis or acute hepatitis) requires a shift from the standard hepatotoxic regimen to one containing **non-hepatotoxic drugs** [1]. **1. Why Streptomycin + Ethambutol is correct:** Most first-line antitubercular drugs (HRZ) are metabolized by the liver and carry a risk of drug-induced liver injury (DILI). **Ethambutol** and **Streptomycin** are the only two primary drugs that are primarily excreted by the kidneys and are **not hepatotoxic** [1]. Therefore, in patients with unstable or severe liver disease, a combination of these two drugs (often supplemented by a fluoroquinolone like Levofloxacin) is the safest choice to avoid further hepatic decompensation. **2. Why the other options are incorrect:** * **Isoniazid (H), Rifampicin (R), and Pyrazinamide (Z)** are all hepatotoxic. * **Pyrazinamide** is the most hepatotoxic, followed by **Isoniazid**, and then **Rifampicin**. * **Options A, C, and D** all contain at least one of these hepatotoxic agents (Isoniazid or Rifampicin), making them unsuitable for patients with severe, unstable liver dysfunction. **Clinical Pearls for NEET-PG:** * **Hepatotoxicity Order:** Pyrazinamide > Isoniazid > Rifampicin. * **WHO Guidelines for Liver Disease [1]:** * *Stable/Mild disease:* 2HRE + 7HR. * *Severe/Unstable disease:* 18–24 months of Streptomycin + Ethambutol + Fluoroquinolone. * **Monitoring:** In standard therapy, if AST/ALT levels rise >3 times the upper limit of normal (ULN) with symptoms, or >5 times ULN without symptoms, all hepatotoxic drugs must be stopped immediately.
Explanation: **Explanation:** The correct answer is **L-Dopa**. While many drugs induce hypertension, L-Dopa is primarily associated with **orthostatic hypotension**. **1. Why L-Dopa is the correct answer:** L-Dopa (Levodopa) is a precursor to dopamine. In the peripheral circulation, dopamine acts on D1 receptors causing vasodilation and on $\beta_1$ receptors in the heart. However, its most significant clinical effect on blood pressure is **hypotension**, occurring in approximately 30% of patients. This is due to both peripheral vasodilation and the inhibition of central sympathetic outflow. **2. Why the other options are incorrect:** * **NSAIDs:** These inhibit cyclooxygenase (COX) enzymes, leading to decreased synthesis of vasodilatory prostaglandins ($PGE_2$ and $PGI_2$). This results in sodium and water retention and increased peripheral vascular resistance, elevating blood pressure. * **Cyclosporine:** This calcineurin inhibitor causes potent renal afferent arteriolar vasoconstriction and increases endothelin production, leading to significant systemic hypertension in up to 50% of transplant patients. * **Erythropoietin (EPO):** EPO-induced hypertension is a well-known side effect in patients with chronic kidney disease. It occurs due to an increase in whole-blood viscosity and direct vasoconstrictive effects on vascular smooth muscle. **Clinical Pearls for NEET-PG:** * **Drug-Induced Hypertension "Hot List":** OCPs (most common cause in young women), Steroids, Licorice, SNRIs (Venlafaxine), and VEGF inhibitors. * **L-Dopa Side Effects:** Remember the "On-Off" phenomenon, dyskinesias, and psychosis. To minimize peripheral side effects like hypotension and vomiting, L-Dopa is always co-administered with a peripheral decarboxylase inhibitor (Carbidopa).
Pharmacokinetics and Pharmacodynamics
Practice Questions
Drug Metabolism and Excretion
Practice Questions
Adverse Drug Reactions and Interactions
Practice Questions
Therapeutic Drug Monitoring
Practice Questions
Pharmacogenomics and Precision Medicine
Practice Questions
Drug Development and Clinical Trials
Practice Questions
Rational Prescribing and Deprescribing
Practice Questions
Medication Adherence Strategies
Practice Questions
Special Populations (Pediatric, Geriatric, Pregnancy)
Practice Questions
Pharmacovigilance
Practice Questions
Get full access to all questions, explanations, and performance tracking.
Start For Free